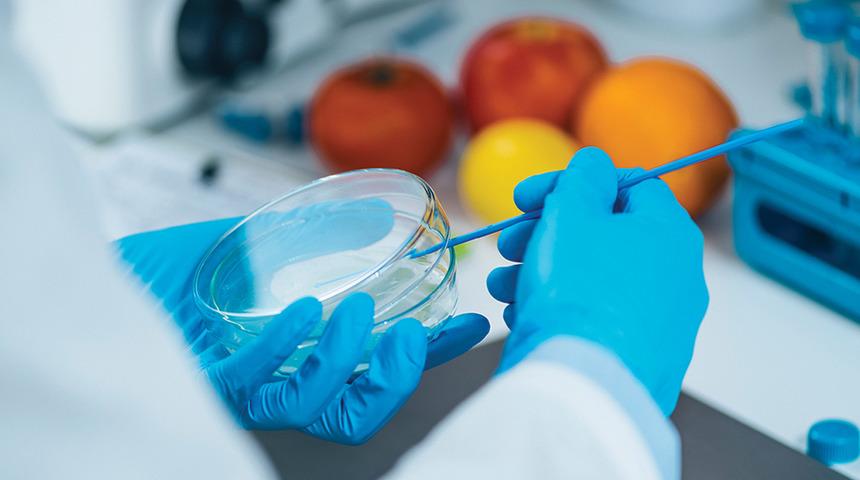
İngiltere laboratuvar üretimi gıdaların satışını iki yıl içinde onaylamayı planlıyor

İngiltere, laboratuvar üretimi gıdaların satışını iki yıl içinde onaylamayı planlıyor. Gıda Standartları Ajansı (FSA), bu tür ürünlerin onay sürecini hızlandırmak için yeni düzenlemeler üzerinde çalışıyor. Hücrelerden üretilen bu gıdalar, küçük kimyasal tesislerde yetiştiriliyor ve çevreye duyarlı alternatifler olarak öne çıkıyor.
Dünyada Singapur, ABD ve İsrail laboratuvar üretimi et satışını onaylayan ülkeler arasında yer alırken, İtalya ile ABD’deki bazı eyaletler bu ürünlere yasak getirdi. İngiltere’deki şirketler, ülkedeki mevcut düzenlemelerin süreci yavaşlattığını ve küresel rekabette geride kaldıklarını savunuyor.

FSA, laboratuvar üretimi gıdaların güvenliğini sağlamak amacıyla bilim insanları ve şirketlerle iş birliği yaparak yeni düzenlemeler geliştirmeyi amaçlıyor. Bazı uzmanlar ise düzenlemelerin şirketlerle ortak hazırlanmasının çıkar çatışması yaratabileceğini öne sürüyor.

Laboratuvar ortamında üretilen gıdalar, bitki veya hayvan hücrelerinden elde ediliyor ve bazen gen düzenleme teknikleri kullanılıyor. Bu ürünlerin çevre dostu ve daha sağlıklı olduğu savunulsa da bazı uzmanlar, üretim süreçlerinin yüksek enerji gerektirdiğini ve sağlık etkilerinin abartıldığını düşünüyor. FSA yetkilisi Prof. Robin May, yeni düzenlemelerin bilime dayanması gerektiğini belirterek, “Bu süreç karmaşık olabilir fakat güvenliği sağlamak için bilimin tam olarak anlaşılması kritik öneme sahip” dedi.
(DHA)